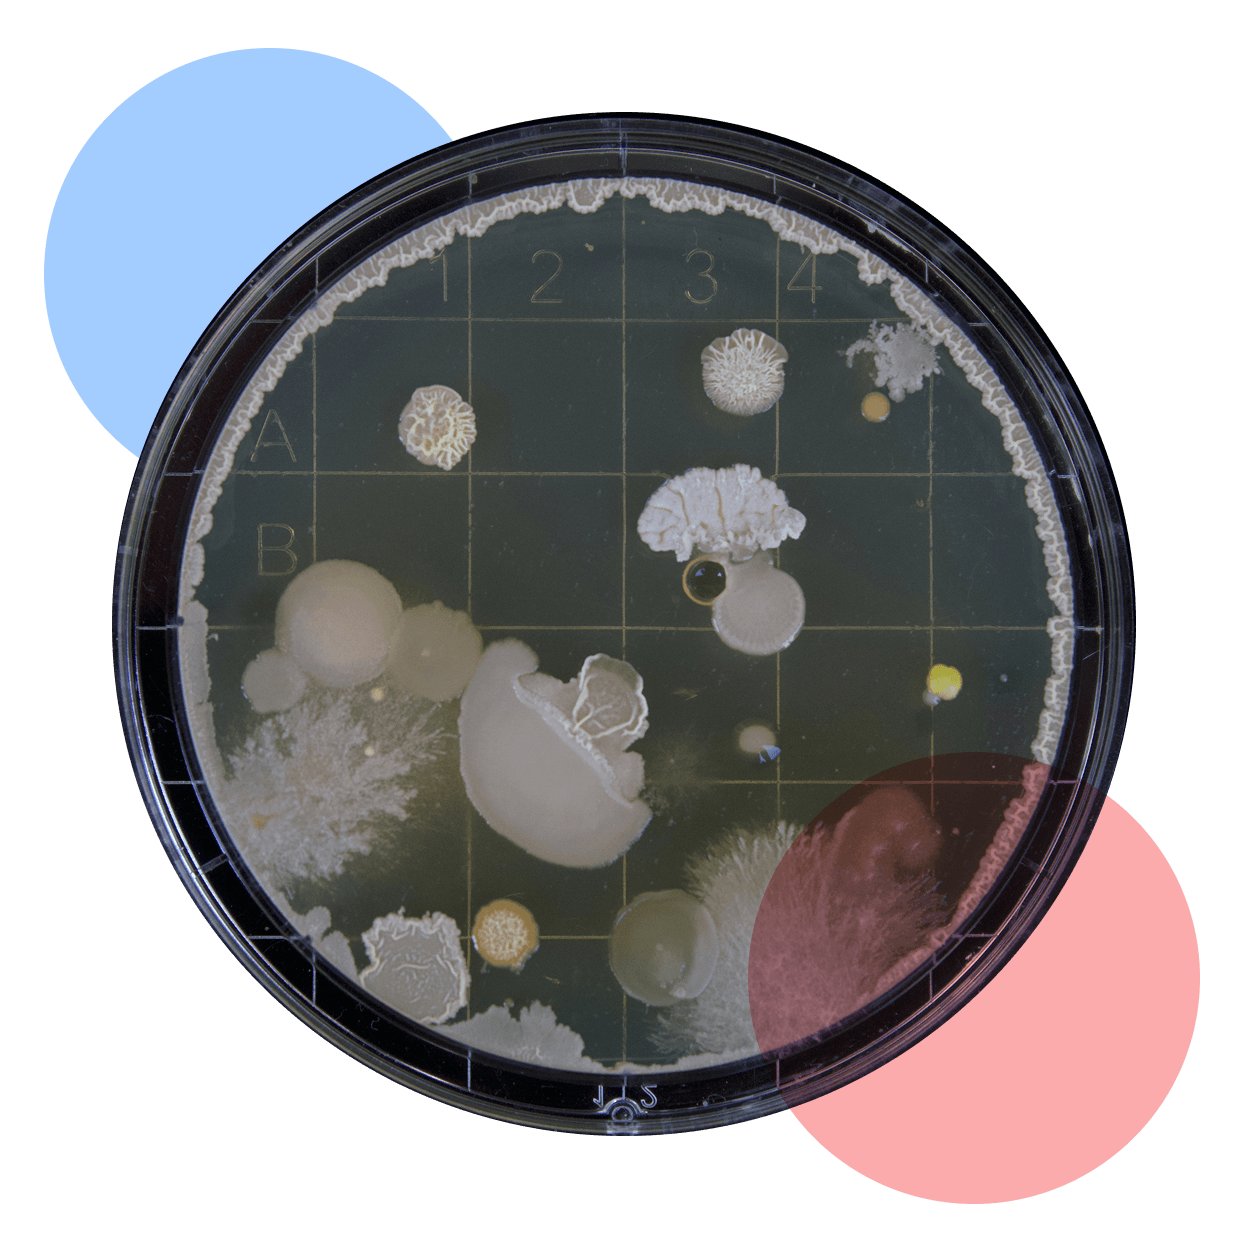

Global Health & Development Program
What we do
Saving and improving lives worldwide
Compared to past generations, many of us can expect longer lives, greater wealth, and more opportunity. But for billions of people, those expectations remain out of reach. Poverty keeps families from accessing healthcare, vaccinations, and education — leaving them more vulnerable to disease and limiting their futures.
Our Global Health & Development Program directs funding where it can have the greatest impact — tackling the world’s biggest inequities in health, wealth, and opportunity. We focus on:
- Significantly improving the lives of the world’s most vulnerable people
- Preventing deaths from easily treatable and preventable diseases
- Supporting systemic, sustainable change that creates lasting opportunity

▲ Photo by Evidence Action DtWI
Our strategy
We focus on funding opportunities that can achieve both scale and proven impact — directing resources where they are most likely to save and improve lives. We aim to be risk-neutral.
We work closely with partners to ensure our funds fill a unique role in the global health and development landscape, complementing rather than duplicating others’ efforts.
We pursue opportunities that most donors can’t access — whether because they are time-sensitive, higher-risk, or overlooked — so that our community can unlock impact that would otherwise be missed.

▲ Photo from Iodine Global Network by UNICEF Madagascar
We seek out the world’s biggest gaps in health and development without limiting ourselves to set problems or regions.
By targeting these gaps, we direct resources where they can do the most good. Some of the inequities we aim to close include:
Nearly half the world lives on less than $6.85 per day
Globally, 1 in 5 children still miss out on essential immunizations
In Nigeria, a pregnant woman is more than 200 times more likely to die in pregnancy or childbirth than a pregnant woman in Sweden
Focus Area
Catalytic Impact
GHD Catalytic Impact Fund
The disruption of U.S. aid in 2025 created both crisis and opportunity — highlighting the urgent need for strategic, leverage-focused funding that creates sustainable change beyond immediate relief.
With the GHD Catalytic Impact Fund, we target opportunities where a relatively small philanthropic investment can create transformative change. Rather than just funding programs that directly help people today, we look for interventions that:
- Trigger systemic improvements: Supporting investments that create lasting infrastructure or increase cost-effectiveness of existing systems
- Remove key bottlenecks: Identifying and eliminating barriers that accelerate progress
- Crowd in capital: Providing early-stage funding that attracts substantial follow-on investment
By prioritizing these leverage points, we help donors maximize their impact in building sustainable, long-term solutions to global poverty and suffering.

▲ Photo from Goal 3's IMPALA Project
Special Projects
Rapid Response Fund
In early 2025, we partnered with The Life You Can Save to launch a Rapid Response Fund addressing urgent funding shortfalls caused by USAID cuts.
Between February and August 2025, the fund raised and deployed over $12M to high-impact organizations — enabling some of the world’s most effective organizations to keep delivering essential services and lifesaving interventions to those who need them most.
This Fund closed on August 31, 2025 and is not accepting donations.

▲ Source: Catholic Relief Services
Help those most in need
Donate now
Catalyze change
Donate to the GHD Program's Catalytic Impact Fund to support high-leverage grants that unlock lasting change.
Power the program
If you are interested in supporting the Global Health & Development Program as a whole, please reach out to funds@founderspledge.com.
Meet the team

Katrina Sill
Program Lead
Katrina is the Global Health and Development Lead at Founders Pledge, where she researches and evaluates high-impact funding opportunities (HIFOs) and manages the GHD Fund. Previously, she was Associate Director at Innovations for Poverty Action’s Right-Fit Evidence Unit, where she advised international development funders and implementers on their data-driven decision making. Before that, she was the Impact Division Director at One Acre Fund Tanzania, where she led applied research to improve the program’s impact portfolio for smallholder farmers. She holds an MPA in International Development from Columbia University and BAs in Anthropology and Communication. In her free time, she enjoys time in the mountains and connecting with value-aligned community.

Caitlin McGugan
Senior Researcher
Caitlin is a development economist specializing in impact evaluations of global health and livelihoods programs. She joined Founders Pledge as a Senior Researcher in May 2025. Caitlin has extensive experience in high-impact grant-making that spans evaluation of early-stage catalytic funding opportunities at USAID’s Development Innovation Ventures and six years as a Senior Researcher at GiveWell. Her work at GiveWell included leading cost-effectiveness research for top charities, and serving as technical adviser to two randomized controlled trials of new global health interventions in Mozambique and Nigeria. Earlier, she worked as an economic consultant for antitrust litigation. Caitlin holds an MA in Economics from Princeton University, where she also pursued doctoral research, and a BA in Economics and Mathematics from Williams College.

Harry Street
Junior Researcher
Harry joined Founders Pledge as a Global Health and Development Research Assistant in September 2024. He graduated with a BSc in Economics from St Andrews, after which he worked as a finance analyst in London. Deciding to switch things up, he then completed his master's at Oxford in Global Health, during which he focused on health economics, calculating the benefits of vaccinations against antimicrobial resistance across sub-Saharan Africa.